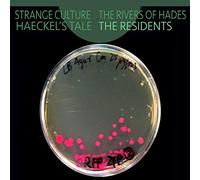
The Residents - Strange Culture/Rivers Of Hade

![The Residents - Theory of Obscurity (Blu Ray) [DVD] [2016] [Italia] [Blu-ray]](https://cdn.comparar.net/offer/es/the-residents-theory-of-obscurity-blu-ray-dvd-2016-italia-blu-ray-200t180683ed665c537c6e1b2e50825998e1bd527712dbf.jpg)
The Residents - Theory of Obscurity (Blu Ray) [DVD] [2016] [Italia] [Blu-ray]
24,49 €
Amazon Marketplace (ES)
Envío a partir de 2,99 €

35,00 €
Amazon Marketplace (ES)
Envío a partir de 5,00 €

12,00 €
Amazon Marketplace (ES)
Envío a partir de 2,99 €

25,94 €
Amazon Marketplace (ES)
Envío a partir de 2,99 €

15,05 €
Amazon Marketplace (ES)
Envío a partir de 2,99 €

35,65 €
Amazon Marketplace (ES)
sin gastos de envío
![The Residents - Mush-Room [VINYL] [Vinilo]](https://cdn.comparar.net/offer/es/the-residents-mush-room-vinyl-vinilo-200t180ed5604905cda0e39e83481372794d06d2c5823c7.jpg)
The Residents - Mush-Room [VINYL] [Vinilo]
99,00 €
Amazon Marketplace (ES)
Envío a partir de 4,00 €

22,62 €
Amazon Marketplace (ES)
sin gastos de envío
![The Residents - Metal, Meat & Bone ~ The Songs Of Dyin' Dog [Vinilo]](https://cdn.comparar.net/offer/es/the-residents-metal-meat-bone-the-songs-of-dyin-dog-vinilo-200t18053ab2cedf6ad950eb83e8603efa08ddbfedb2cfc.jpg)
38,95 €
Amazon Marketplace (ES)
Envío a partir de 2,99 €

22,51 €
Amazon Marketplace (ES)
Envío a partir de 2,99 €

30,88 €
Amazon Marketplace (ES)
Envío a partir de 3,79 €

539,00 €
Amazon Marketplace (ES)
Envío a partir de 5,00 €

24,01 €
amazon.es
Envío a partir de 2,99 €

24,30 €
Amazon Marketplace (ES)
sin gastos de envío
52,19 €
Amazon Marketplace (ES)
sin gastos de envío

22,39 €
amazon.es
sin gastos de envío

41,41 €
amazon.es
sin gastos de envío

27,91 €
amazon.es
sin gastos de envío

14,28 €
amazon.es
Envío a partir de 0,99 €

13,37 €
amazon.es
Envío a partir de 0,99 €

88,01 €
Amazon Marketplace (ES)
sin gastos de envío

14,53 €
amazon.es
Envío a partir de 0,99 €

62,60 €
amazon.es
sin gastos de envío

35,36 €
amazon.es
sin gastos de envío

The Residents of Willowpond Manor
11,80 €
amazon.es
Envío a partir de 0,99 €

36,05 €
amazon.es
sin gastos de envío

The Residents of Shiny Landing: We All Got Problems But Not Like These
13,66 €
amazon.es
Envío a partir de 0,99 €

48,51 €
amazon.es
sin gastos de envío

WELCOME TO THE FREED PEOPLE - OR - RESPONSIBILITIES OF THE BLACK RESIDENTS OF THE DISTRICT OF COLUMBIA BY Daniel A. Payne AND THE HISTORY OF THE BLACK CHURCH BY CARTER G. WOODSON, Ph.D.
10,56 €
amazon.es
Envío a partir de 0,99 €

29,06 €
amazon.es
sin gastos de envío

Life in West China: Described by Two Residents in the Province of Sz-Chwan
27,81 €
amazon.es
sin gastos de envío

The Residents - Residue Of The Residents
82,00 €
Amazon Marketplace (ES)
Envío a partir de 5,00 €

My Senior Residents Witty and Wise Quotes Journal: A creative keepsake to preserve the unforgettable words, humor, and insights of the remarkable seniors in your life.
8,31 €
amazon.es
Envío a partir de 0,99 €

Mark of the Mole / Intermission by RESIDENTS
147,00 €
Amazon Marketplace (ES)
Envío a partir de 5,00 €

SnuggleStars A Cozy Space Coloring Book: A cozy space-themed coloring book starring the adorable animal residents of Whiskerwood, perfect for fans of ... gentle whimsy, and of course..magical skies!
8,95 €
amazon.es
Envío a partir de 0,99 €

16,73 €
ebay.es
sin gastos de envío
![The Residents - Play Wormwood [Francia] [DVD]](https://cdn.comparar.net/offer/es/the-residents-play-wormwood-dvd-the-residents-importacion-usa-200t1801c07480d55d23582401e09fbccbdde4eb1ba2e2f.jpg)
16,64 €
ebay.es
sin gastos de envío

16,73 €
ebay.es
sin gastos de envío

16,73 €
ebay.es
sin gastos de envío

17,39 €
ebay.es
sin gastos de envío
Denunciar contenido ilegal
- 1
- 2
- 3
- 4
- página siguiente
🤖 Pregunta a ChatGPT
🛍️ ¿Cuáles son los criterios de compra más importantes?
💰 ¡Dime cuáles son las mejores ofertas!
📋 ¡Haz un breve resumen!
Información acerca de "the residents of"
Analiza las 324 los precios para "the residents of".
Hemos encontrado productos de 10 categorías, con un rango de precio entre 0,46 € y 599,00 €.
Datos de "the residents of"
- El producto que deseas, "the residents of", está disponible en 7 tiendas online, como Amazon Marketplace (ES), amazon.es, eneba.com (ES) marketplace y casadellibro.com.
- De entre todos los fabricantes puedes seleccionar 8 vendedores, entre los que destacan Universal Music Group, Bandai, Nintendo y Cambridge University Press.
- Con un precio aproximado de 18,00 € - 18,99 € se encuentra el mayor número de recomendaciones (16).
- Además, también pueden interesarte .
- Con nuestra amplia paleta de colores puedes encontrar el artículo que buscas en tu color favorito. De entre las 0 tonalidades disponibles, el color es el más utilizado.
No olvides tu cupón descuento:
Denunciar infracción
Está a punto de denunciar una infracción legal en base a la Ley de Servicios Digitales de la UE.